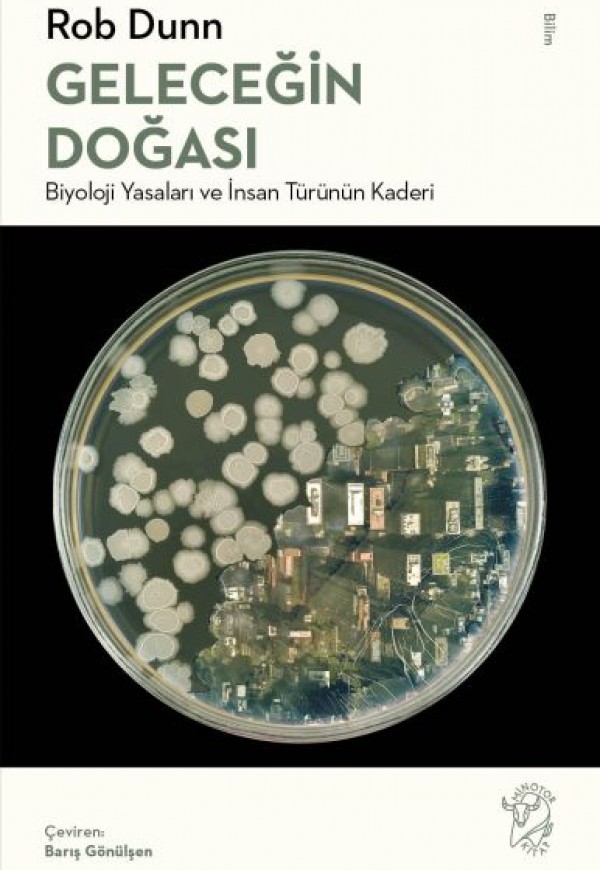

Geleceğin Doğası: Biyoloji Yasaları ve İnsan Türünün Kaderi
Geleceğin Doğası: Biyoloji Yasaları ve İnsan Türünün Kaderi
- Stok Durumu: Stokta var
- Marka: Minotor Kitap
- Ürün Kodu:: 9786057106193
Satış Sayısı: 0
Görüntülenme Sayısı: 17
350,00TL
Vergiler Hariç: 350,00TL
Dünyanın önde gelen ekologlarından Rob Dunn, Dünya denen bu narin gezegende hayatta kalacaksak insanlığın onun değişmez yasalarını anlaması ve bu yasalara uyması gerektiğini savunuyor.
Türümüz doğa hakkında şimdiye kadar örneği görülmemiş çeşit ve miktarda bilgi topladı, fakat bu bilgiyi yaşamı hâkimiyeti altına almak ve gezegeni iradesine boyun eğdirmek için kullandı. Geleceğin Doğası’nda Rob Dunn bu türden çabaların beyhude olduğunu ileri sürüyor. Kendimizi yaşamın ve doğanın efendisi gibi görüyor olabiliriz, halbuki aslında onun insafına kalmış durumdayız. Antibiyotik direncinde, doğal seçilimin biyoçeşitlilik üretme kudretinde ve hatta Londra Metrosu’nun şaşırtıcı yeraltı dünyasında Dunn, hiçbir insan faaliyetinin ortadan kaldıramayacağı yaşam kanunları buluyor. Yapay ekin adacıkları yarattığımızda, doğaya toksik atıklarımızı boca etiğimizde veya çeşitli topluluklar kurduğumuzda, aslında kadim yasaların işleyişine yeni malzemelerle katkıda bulunmaktan başka bir şey yapmıyoruz. Gelecekte Dünya üzerinde yaşamın serpilip gelişeceğinde en ufak bir kuşku yok, ama insan türünün geleceği hayli kuşku altında.
Edward Wilson’ın Sosyobiyoloji’si kadar iddialı ve Elizabeth Kolbert’in Altıncı Yok Oluş’u kadar vakitli bir kitap olan Geleceğin Doğası, yaşamın çeşitlilik ve kaderini anlamak için yeni bir standart ortaya koyuyor.
Ürün Adı: Geleceğin Doğası: Biyoloji Yasaları ve İnsan Türünün Kaderi
Ürün Kodu: 9786057106193
Yazar: Rob Dunn
Basım Yılı: 2022
Kapak Türü: Karton Kapak
Sayfa Sayısı: 320
Kağıt Cinsi: 2. Hamur
Çevirmen: Barış Gönülşen
Türümüz doğa hakkında şimdiye kadar örneği görülmemiş çeşit ve miktarda bilgi topladı, fakat bu bilgiyi yaşamı hâkimiyeti altına almak ve gezegeni iradesine boyun eğdirmek için kullandı. Geleceğin Doğası’nda Rob Dunn bu türden çabaların beyhude olduğunu ileri sürüyor. Kendimizi yaşamın ve doğanın efendisi gibi görüyor olabiliriz, halbuki aslında onun insafına kalmış durumdayız. Antibiyotik direncinde, doğal seçilimin biyoçeşitlilik üretme kudretinde ve hatta Londra Metrosu’nun şaşırtıcı yeraltı dünyasında Dunn, hiçbir insan faaliyetinin ortadan kaldıramayacağı yaşam kanunları buluyor. Yapay ekin adacıkları yarattığımızda, doğaya toksik atıklarımızı boca etiğimizde veya çeşitli topluluklar kurduğumuzda, aslında kadim yasaların işleyişine yeni malzemelerle katkıda bulunmaktan başka bir şey yapmıyoruz. Gelecekte Dünya üzerinde yaşamın serpilip gelişeceğinde en ufak bir kuşku yok, ama insan türünün geleceği hayli kuşku altında.
Edward Wilson’ın Sosyobiyoloji’si kadar iddialı ve Elizabeth Kolbert’in Altıncı Yok Oluş’u kadar vakitli bir kitap olan Geleceğin Doğası, yaşamın çeşitlilik ve kaderini anlamak için yeni bir standart ortaya koyuyor.
Ürün Adı: Geleceğin Doğası: Biyoloji Yasaları ve İnsan Türünün Kaderi
Ürün Kodu: 9786057106193
Yazar: Rob Dunn
Basım Yılı: 2022
Kapak Türü: Karton Kapak
Sayfa Sayısı: 320
Kağıt Cinsi: 2. Hamur
Çevirmen: Barış Gönülşen
Yorumlar
Yorum YapınızYayınevinin Diğer Kitapları
Kadınların sessiz kalmasını tercih eden bir toplumda kadın bir yazarın kendi sesini bulma öyküsü, sanatçının genç bir kadın olarak portresi…Yokluğumda..
300,00TL
Vergiler Hariç:300,00TL
İş kaynaklı stres ve tükenmişliğin artık salgına dönüştüğü, güvencesizlik ve düşük ücretlerin işgücü piyasasında kural haline geldiği günümüzde, açıkt..
150,00TL
Vergiler Hariç:150,00TL
Financial Times Yılın KitabıGuardian Yılın KitabıNew Statesman Yılın KitabıBinlerce yıldır, egemen toplumların içten içe kendilerinin en iyisi olduğun..
375,00TL
Vergiler Hariç:375,00TL
“Metni kadın yazmadı. Metni kadın yazdı ama yazmamalıydı. Metni kadın yazdı ama baksana ne hakkında yazmış. Metni kadın yazdı ama o aslında gerçek bi..
300,00TL
Vergiler Hariç:300,00TL
Gösterişçilik nedir? Onu neden hor görürüz? Ve daha tartışmalı bir soru soracak olursak: Gelişmekte olan bir kültür için gösterişçilik neden hayati ön..
250,00TL
Vergiler Hariç:250,00TL
Dünyada gezinmeye, kaybolmaya ve bilinmeyenin kullanım alanlarına dair ilham verici bir keşif seferi. Bir dizi otobiyografik deneme yazısı olarak kale..
280,00TL
Vergiler Hariç:280,00TL
“Ülkemizdeki çeviri kitap tanıtımlarında, eleştirilerinde ve edebiyat çevirisi araştırmalarında da çevirmenin varlığını yadsımayan bu bakış açısının y..
250,00TL
Vergiler Hariç:250,00TL
“Bir edebiyat metnini yazıldığı dilden başka bir dilde yeniden yazmak ve okumak, yaratıcı ve büyüleyici bir süreçtir. Yaratıcıdır, çünkü çevirmen o ed..
250,00TL
Vergiler Hariç:250,00TL
Psikanalitik vaka sunumları ile yazarının kişisel deneyimlerini Lacancı teoriyle harmanlayan bu aydınlatıcı kitap, çağdaş öznelliği anlamaya çalışırke..
250,00TL
Vergiler Hariç:250,00TL
Anılar hiç beklemediğimiz bir anda içimizde şiddetli duygular uyandırır: bir hüznün sancısı, bir aşkın telaşı, bir kaybın acısı, bir pişmanlığın huzur..
300,00TL
Vergiler Hariç:300,00TL
“Umutluyum, çünkü yoksulluğun nedenleri, iklim değişikliği gerçeği ya da kadınların eşitliği söz konusu olduğunda hakikati anlatan, bizim hikâyelerimi..
300,00TL
Vergiler Hariç:300,00TL
“Tüm imgeler arasında, alev imgeleri şiirden bir işaret taşırlar. Alev karşısında hayal kuran herkes gücül bir şairdir. Alev karşısında dalınan her hü..
200,00TL
Vergiler Hariç:200,00TL
“Tilki pek çok şey bilir, kirpi ise tek bir büyük şey.”İngilizce yazan eleştirmenlerin çok azı Rus düşüncesi ve kültürü hakkında Isaiah Berlin kadar f..
500,00TL
Vergiler Hariç:500,00TL
“On bin yıl ya da on milyon yıl sonra dünya nasıl bir yer olacak? Bizim hakkımızda ne tür hikâyeler anlatılacak?”Ayak İzleri: Geleceğin Fosillerinin P..
350,00TL
Vergiler Hariç:350,00TL
“Bu küçük kitabın felsefi amacı, çağdaş bilimsel düşünceyi kendi diyalektiği içinde kavramak ve böylece taşıdığı özsel yeniliği göstermektir.”Yeni Bil..
225,00TL
Vergiler Hariç:225,00TL
“İki bin yıllık sansür tarihinde büyüleyici bir gezinti.”—The Financial Timesİlk Çin imparatorunun kitaplara açtığı savaştan Vatikan’ın pornografi “ya..
440,00TL
Vergiler Hariç:440,00TL
Tekinsizlik ve yalnızlığı psikanalitik kuram ve uygulamalardan yola çıkarak, pandeminin gölgesinde yeniden düşündüren ve tartıştıran bir kitap.İstanbu..
250,00TL
Vergiler Hariç:250,00TL
Etkin görüşmeler yapabilmek için pratik stratejileri ele alan klasik bir çalışma!Klinik Görüşme, alan deneyimleri ve akademisyenlikleriyle ABD’de çok ..
800,00TL
Vergiler Hariç:800,00TL
Ürün Adı: Suret Sayı: 13 – Psikokültürel Analiz – SahneÜrün Kodu: 2016000021066Yazar: KolektifBasım Yılı: Kapak Türü: Sayfa Sayısı: 0Kağıt Cinsi: Çevi..
140,00TL
Vergiler Hariç:140,00TL
Werner Jaeger, Parmenides, Herakleitos, Empedokles gibi karanlık ve zor düşünürlerin metinlerini ayrıntılı bir şekilde yorumlarken,Tanrı düşüncesinin ..
350,00TL
Vergiler Hariç:350,00TL




















